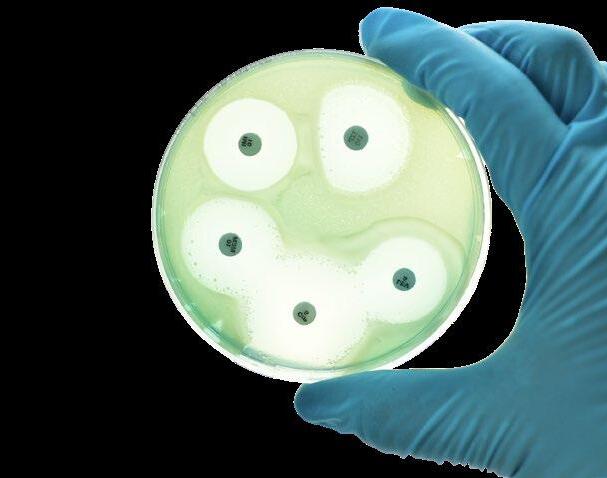
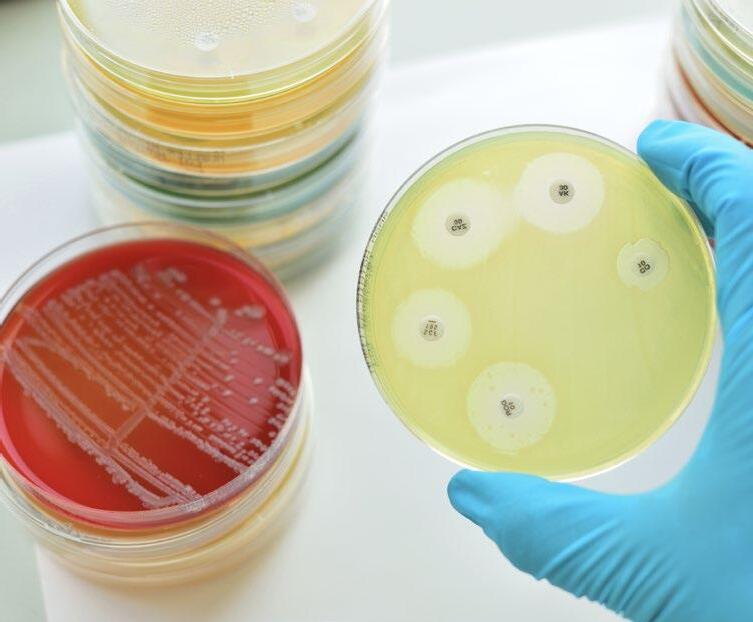

![]()


As our industry continues to seek alternatives to antibiotics and improve efficiency across all species, the spotlight has turned to an ancient yet powerful ally: the microbiota.
This issue of nutriNews explores the growing field of prebiotics and probiotics —tools that are transforming how we approach gut health and productivity in poultry, swine, and cattle
With mounting evidence linking intestinal integrity to immune resilience, growth performance, and feed efficiency, microbial management is no longer a niche strategy—it’s a core pillar of modern animal nutrition
Alongside this main theme, we present a robust lineup of articles addressing critical challenges and emerging innovations in the field.
Learn how nutritional interventions can support fertility in male broiler breeders, and explore the potential of hybrid rye as a sustainable ingredient in laying hen diets. Discover how organic acids provide a natural pathway to health in poultry production.
On the swine side, we dive into phosphorus metabolism, the impact of oxidized fatty acids, and the crucial role of minerals in hoof health during gestation each a vital piece in optimizing sow performance and longevity.
Finally, we turn to ruminants, where enzyme supplementation continues to unlock fiber digestibility and feed efficiency in an evolving regulatory and environmental landscape.
Whether you’re a formulator, veterinarian, or feed industry professional, we hope this issue provides insights to help you meet the demands of today’s production systems—with precision, sustainability, and innovation.
Enjoy the read!
Gustavo Quintana-Ospina Technical Coordinator nutriNews International

EDITOR
COMMUNICATION GROUP AGRINEWS LLC
ADVERTISING
Luis Carrasco +(34) 605 09 05 13 lc@agrinews.es
Ana María Delgado +(34) 600736550 ana@agrinewsgroup.com
SALES DEPARTMENT
Gustavo Lander +(34) 664 66 06 05 int@grupoagrinews.com
Ivan Martos +(34) 664 66 06 02 im@grupoagrinews.com
CUSTOMER SUPPORT
Mercé Soler
EDITORIAL STAFF
Álvaro José Guzman Gustavo Quintana
TECHNICAL DIRECTION
Dr. Edgar Oviedo (poultry)
info@grupoagrinews.com nutrinews.com grupoagrinews.com
Free distribution magazine AIMED AT VETERINARIANS AND TECHNICIANS
Subscription price 125$
nutriNews International
Legal Deposit B15281-2024
ISSN PRINTED VERSION 2938-8910
ISSN DIGITAL VERSION 2938-8929
Images: Noun Project / Freepik/Dreamstime
Synergistic Benefits of Prebiotics and Probiotics in Poultry, Swine, and Cattle Nutrition


Gustavo Quintana-Ospina
Techincal Coordinator, nutriNews

A Day in the Life of Phosphorus in the Pig – Part I

Alberto Morillo Alujas1 and Rafael Duran Gimenez-Rico2
1Doctor of Veterinary Medicine and Consultant at Tests and Trials, S.L.U.
2Regional Techincal Manager, Danisco Animal Nutrition (IFF)
Minerals and Hoof Health of a Pregnant Sow

Juan Gabriel Espino Independent Nutritionist
The Use of Oxidized Fats in Swine Feeding: The Breeding Herd. Part II



Gerardo Ordaz Ochoa, María Alejandra Pérez Alvarado, Luis Humberto López Hernández
National Center for Disciplinary Research in Animal Physiology and Improvement, INIFAP, Mexico

Hybrid Rye Potential in Laying Hen Feed Rations

Gwendolyn Jones PhD., Freelance Journalist
Edgar Oviedo-Rondón PhD, North Carolina State University 44 Nutritional Interventions to Improve Fertility in Male Broiler Breeders


The Use of Organic Acids in Poultry: A Natural Path to Health and Productivity

M. Naeem PhD., Postdoctoral Fellow, Auburn University
Use of Enzymes in Diets for Ruminants: Catalyzing the Efficiency and the Sustainability in the Livestock Production

Braulio de la Calle Campos TD Ruminants Coren Agroindustrial SAU and Head of the Beef Cattle Department at Coren Cooperative Society

Gustavo Quintana-Ospina Technical Coordinator, nutriNews International

The livestock industry continues to seek sustainable strategies to improve animal health, growth performance, and production efficiency while reducing reliance on antibiotics.
Among the most promising approaches are the use of functional feed additives such as prebiotics and probiotics. These bioactive components enhance gastrointestinal health, improve feed efficiency, and support immune function across poultry, swine, and ruminants.

This article explores the mechanisms, evidence-based benefits, and practical applications of prebiotics and probiotics in commercial animal production
Probiotics are live microorganisms, primarily beneficial bacteria and yeasts, which confer health benefits on the host when administered in adequate amounts. Common strains include Lactobacillus, Bifidobacterium, Bacillus, and Saccharomyces cerevisiae
Prebiotics, on the other hand, are non-digestible feed ingredients typically oligosaccharides like fructo-oligosaccharides (FOS), galacto-oligosaccharides (GOS), and mannan-oligosaccharides (MOS)—that selectively stimulate the growth
Together, they form a synbiotic relationship, wherein the prebiotic component nourishes the probiotic organisms, enhancing their survival and activity in the gut.

In poultry, the gastrointestinal tract (GIT) is critical for nutrient absorption and immune defense. Probiotics such as Bacillus subtilis and Lactobacillus acidophilus help maintain a balanced gut flora, inhibit pathogens like Salmonella and Clostridium perfringens, and reduce intestinal inflammation.
Prebiotics like MOS have been shown to prevent pathogen adhesion to the intestinal mucosa by mimicking receptor sites, thereby reducing colonization by harmful bacteria.
In the other hand, improving growth performance and feed efficiency is a cornerstone of modern poultry production, especially in antibiotic-free systems.
The inclusion of prebiotics and probiotics in broiler and layer diets has been consistently linked to improved weight gain, better feed conversion ratios (FCR), and reduced mortality.
These benefits arise from enhanced digestive function, more stable intestinal microflora, and improved nutrient absorption.
Supplementation with prebiotics (e.g., mannan-oligosaccharides, fructooligosaccharides) and probiotics (e.g., Bacillus subtilis, Lactobacillus acidophilus) enhances gut microbial balance by suppressing pathogenic bacteria and promoting beneficial flora. This shift leads to:
Lower energy losses from immune activation and inflammation
Reduced incidence of subclinical infections, especially in the early growth phases
Greater nutrient availability and uptake, contributing to lean muscle development

Numerous studies and commercial trials have shown improvements of 3–8% in average daily gain (ADG) and 2–5% in FCR in broilers supplemented with pre- and probiotics.
Additionally, Probiotics improve the activity of digestive enzymes such as amylase, protease, and lipase. Simultaneously, prebiotics stimulate microbial fermentation, increasing the production of shortchain fatty acids (SCFAs), which nourish enterocytes and promote gut health.
Together, these mechanisms enhance the digestibility of:
Crude protein and amino acids (improving nitrogen retention)
Starch and non-starch polysaccharides (increasing energy utilization)

During stress conditions—such as heat, vaccination, transport, or feed transitions—birds often experience reduced appetite and compromised digestion.
Calcium and phosphorus (via phytate degradation and pH modulation)

Improved nutrient digestibility leads to more efficient feed utilization, reduced feed cost per kilogram of gain, and more uniform bird weights at processing.
Prebiotics and probiotics help maintain feed intake, gut integrity, and microbiota balance during these times, minimizing performance dips and supporting recovery.
For example, Saccharomyces cerevisiae and Lactobacillus strains have been shown to:
Maintain villus height and gut morphology during heat stress
Reduce corticosterone levels and oxidative stress markers
Improve resilience and consistency in performance


As many poultry operations move away from antibiotic growth promoters (AGPs), the need for functional alternatives has grown. Prebiotics and probiotics offer a natural, effective strategy to maintain performance metrics in no-antibiotics-ever (NAE) programs.
Their inclusion helps:
Close the performance gap left by AGP withdrawal
Reduce feed-related digestive upsets
Stabilize litter conditions by lowering pathogen shedding and moisture content

Probiotics also stimulate mucosal immunity by enhancing immunoglobulin A (IgA) secretion and activating macrophages. In laying hens and breeders, improved immune competence translates to better vaccine response and reduced vertical transmission of pathogens.
In layers, the inclusion of Lactobacillus plantarum and yeast-based probiotics has been linked to improved egg production rates, eggshell strength, and yolk pigmentation, likely due to better nutrient absorption and metabolic efficiency.


Weaning is a critical stress period in piglets, often associated with diarrhea and growth setbacks. Supplementation with probiotics such as Enterococcus faecium or Bacillus coagulans helps stabilize the gut flora, reduce post-weaning diarrhea, and support epithelial barrier integrity.
Prebiotics like inulin and FOS increase the abundance of beneficial bacteria such as Lactobacillus and Bifidobacterium, enhancing gut maturation and nutrient uptake.
Functional feed additives enhance resilience to respiratory and enteric pathogens by modulating cytokine profiles, reducing oxidative stress markers, and improving lymphocyte proliferation.
In swine nutrition, maximizing nutrient digestibility is essential for improving feed efficiency, reducing feed costs, and enhancing animal health—especially in antibiotic-free production systems.
Prebiotics and probiotics play a key role in this regard by enhancing digestive function and gut morphology while modulating microbial populations to favor nutrient assimilation.
Probiotics, particularly strains of Lactobacillus, Bacillus, and Enterococcus, have been shown to increase the activity of digestive enzymes such as:
Amylase (for carbohydrate digestion)

Protease (for protein hydrolysis)
Lipase (for fat emulsification and absorption)

When combined with prebiotics like fructo-oligosaccharides (FOS), galactooligosaccharides (GOS), or inulin, the gut microbiota shifts toward more fermentative and fiber-degrading species. This fermentation process results in the production of short-chain fatty acids (SCFAs), such as acetate, propionate, and butyrate, which:
Serve as an energy source for enterocytes
Stimulate gut cell proliferation and turnover
Lower gut pH to enhance mineral solubility and absorption (e.g., calcium, phosphorus, zinc)
Prebiotics and probiotics also promote the development of healthier intestinal architecture. Supplemented pigs often show:
Increased villus height, which boosts the surface area for nutrient absorption
Decreased crypt depth, indicating lower epithelial turnover and reduced inflammation
Greater expression of nutrient transporter genes (e.g., SGLT1 for glucose, PEPT1 for peptides)

This morphological improvement leads to enhanced absorption of amino acids, fatty acids, and micronutrients and supports a more efficient digestive tract, especially under challenging conditions such as weaning or heat stress.
Probiotic supplementation has also demonstrated efficacy in reducing Escherichia coli feces, improving overall biosecurity and reducing zoonotic risk.
One major nutritional challenge in pig diets—especially corn–soybean meal-based rations—is the presence of and other minerals, reducing their bioavailability.
Prebiotics

phytase-producing bacteria gut, contributing to endogenous phytate breakdown.

Moreover, by lowering intestinal pH, prebiotics and probiotics facilitate:
Increased solubility of inorganic phosphorus and calcium
Enhanced efficacy of exogenous phytase enzymes, widely used in swine diets
Improved phosphorus digestibility, critical for bone development and lean gain
carbohydrates can undergo undesirable fermentation in the hindgut, leading to toxic metabolites (e.g., ammonia, biogenic amines). Probiotics and prebiotics suppress such proteolytic fermentation by:
Promoting saccharolytic bacteria like Bifidobacteria

Inhibiting opportunistic pathogens such as Clostridium perfringens
Reducing mucosal irritation and nutrient loss due to inflammation
These effects translate into better overall feed efficiency and a lower incidence of digestive upsets like post-weaning diarrhea.

The efficacy of probiotics depends heavily on strain specificity, viability under feed processing conditions, and resistance to gastric acids and bile. Multistrain formulations may offer broader benefits, but compatibility and dosage must be optimized.


Prebiotics are typically included at 0.1–0.5% of diet dry matter, while probiotics are added based on CFU (colony-forming units), usually ranging from 10⁶ to 10⁹ CFU/g of feed. Delivery through feed, water, or microencapsulation improves stability and targeting.
Feed regulations vary by country. In the U.S., GRAS (Generally Recognized As Safe) status applies to many probiotic strains, but proper registration and product labeling are essential for legal compliance and customer trust.

Probiotics and prebiotics can be used synergistically with enzymes, organic acids, and phytogenics. However, attention must be paid to potential interactions with antimicrobials, which may inhibit probiotic activity.
The return on investment (ROI) for prebiotic and probiotic use is often justified by improvements in:
Feed conversion and growth rates.
Reduced mortality and disease treatments.
Better carcass traits or milk yield.
Improved product quality (egg integrity, meat pH, etc.).
Meta-analyses across species consistently show net positive economic returns, especially when integrated into precision nutrition and health management programs.
The incorporation of prebiotics and probiotics in livestock feeding programs offers multifaceted benefits, from promoting gut health and growth performance to reducing pathogen pressure and enhancing immunity.
As consumer demand for antibiotic-free and sustainable animal products grows, these functional feed additives stand as vital tools for future-ready animal agriculture. When used correctly and in synergy with other nutritional strategies, prebiotics and probiotics can transform the productivity, welfare, and profitability of poultry, swine, and cattle operations.
Emerging trends include the use of:
Next-generation probiotics: Including Faecalibacterium, Akkermansia, and spore-forming strains with enhanced gut resilience.
Postbiotics: Non-viable microbial products and metabolites that exert health benefits, bypassing stability concerns.
Precision microbiome management: Leveraging genomic tools to tailor microbiome support by production phase, environment, and animal genotype.
Innovations in microencapsulation, nanotechnology, and real-time gut microbiota monitoring will further enhance the strategic use of these additives in livestock nutrition.




Alberto Morillo Alujas 1 and Rafael Duran Giménez-Rico 2
1Doctor of Veterinary Medicine and Consultant at Tests and Trials, S.L.U.
2Regional Technical Manager, Danisco Animal Nutrition (IFF).

Phosphorus (P) is the second most abundant mineral in animals after calcium (Ca). In pigs, 77% of P is found in bones, while the rest is distributed in organic fluids and tissues, participating in various biological functions.
This article explores the importance of phosphorus in the health and metabolism of pigs, as well as the implications of its dietary and environmental management.



Phosphorus (P) is the second most abundant mineral in animals after calcium (Ca) in a fixed ratio P: Ca, approximately 80% is found in bones and teeth, while the remaining 20% is distributed in organic fluids and tissues, participating in various biological functions.
In pigs, approximately 77% of P is found in the bones, compared to 99% of Ca. The proportion of P in bones varies depending on the state of the bone, constituting 18% of bone ash, 10% of dry, fat-free bone, and 4.5% of wet bone.
P plays a vital role in a number of metabolic functions:
Utilization and transfer of energy through AMP, ADP,ATP and phosphocreatine, which are involved in gluconeogenesis.
Transport of fatty acids.
Protein synthesis.
Sodium-potassium pump activity.
Appetite control and feed conversion efficiency.
On the other hand, P is part of RNA and DNA molecules, being essential for cell growth and differentiation, and, associated with lipids, it is part of phospholipids that contribute to the fluidity of cell membranes and the myelination of nerves.
In the extracellular fluid, approximately 30% of P circulates as orthophosphate, PO43 and helps maintain osmotic pressure, acid-base balance, neuronal activity, and appetite.

In general, P stores in the body can be thought of as a small circulating reservoir (body fluids) for short-term vital functions and a large deposit in the skeleton.

The skeleton, through continuous deposition and resorption, provides finite buffering capacity to maintain constant levels in soft tissues.
P requirements are estimated together with Ca requirements and cannot be estimated separately. However, for educational reasons, the implications of Ca will be ignored in this article.
Elemental P is highly reactive and is converted to phosphate when exposed to air, which is the nutritionally relevant form of P for plants and animals, obtained mainly from phosphate rock, a non-renewable, finite resource.
Inadequate P management in animal feed can result in low productivity due to P deficiency or excess
Excessive supply can cause leaching of P through waterways, leading to serious ecological consequences such as eutrophication of waters that favors the growth of toxic nitrogenfixing algae or cyanobacteria.
Due to hormonal regulation, plasma P values do not always reflect the mineral status of the animal, as they fluctuate widely in healthy animals and simply reflect the balance between inputs and outputs. Despite this, they are considered normal values:
2.6-3.2 mmol for animals weighing
P increases after ingestion and is reduced by stress.
In this regard, a study conducted by Bautista et al. (2010) applying P intramuscularly to pigs at 3 days of age and at weaning confirmed the relationship between stress, phosphatemia, and growth rate, as the animals obtained better weight gains (+58 g/d) and reached slaughter weight with 8.5 kg more live weight.
The relationship between inositol, phytic acid, and phytate in plant P is fundamental in plant nutrition and biochemistry.
Inositol (cyclohexane-hexol; C6H12O6) is a polyol alcohol of the cyclohexane ring and the main component of phytic acid.

The most common isomer of inositol is myo-inositol, a biologically active form similar to glucose.

The phosphorylation of myo-inositol gives rise to phytic acid, an efficient process for storing large amounts of P in a compact molecule.
Myo-inositol is abundant in cereal grains and soybean by-products.
It is efficiently absorbed in the small intestine of pigs and distributed to various tissues, including liver cells and muscles, playing a crucial role in cellular and biological functions such as:
Cell signaling.
Lipid metabolism.
Insulin regulation.
Phytic acid or inositol hexaphosphate (PI6) is a molecule composed of an inositol ring to which 6 phosphate groups are attached, being the main form of P storage in seeds and grains, representing up to 90% of total P in seeds.
Phytates are the salts of phytic acid that form when they bind to cations, proteins, amino acids, and starch to increase their chemical stability. They are essential for seed germination as they form part of hormones such as abscisic acid and gibberellins, which are necessary for this process.
They are soluble at acidic pH and recombine at basic pH, a fundamental characteristic in animal nutrition.
P bound to phytate (282g kg-1 of P in phytate), commonly referred to as phytic P, is only partially degradable in pigs due to:
Minimal secretion of endogenous phytase throughout the gastrointestinal tract.
The unfavorable chemical environment of a complete diet.

Phytic acid binds weakly to biand trivalent cations under acidic conditions in the stomach and precipitates as phytate at the neutral pH of the small intestine, inhibiting the intestinal absorption of trace elements and therefore considered an antinutrient.
The concentration of phytate in the diet determines the magnitude of the animal's response to exogenous phytase supplementation.



Figure 1. Structure of inositol (1), phytic acid (2) and phytate (3A) at neutral pH and (3B) chelated with different cations.
Inositol (Myo-inositol)
Inositol monophosphate
Inositol diphosphate
Inositol triphosphate
Inositol tetraphosphate
Inositol tetraphosphate
Inositol pentaphosphate
Inositol hexaphosphate (phytic acid, IP6)
Calcium phytate Magnesium phytate
complex
Phytin is a mixture of phytic acid and its Ca, magnesium, and potassium salts, and is a special form of phytate found in plants. Not all phytates are phytin, as it is a specific form of phytate.
Varieties of cereals and oilseeds have been developed to reduce the concentration of phytate and increase the bioavailability of P in feed.
For example, P digestibility in low-phytate corn was approximately 26 percentage points higher than in normal corn, and P bioavailability in low-phytate soybean meal was 12 to 26 percentage points higher than in conventional soybean meal.

PHYTIC PHOSPHORUS
Phytic phosphorus (PP, Phytic Phosphorus) comes from from phytic acid and phytates, and is a form of p storage in plants, especially in seeds and grains, constituting up to 60-80% of total phosphorus in plants.
It has low bioavailability for pigs, as they lack sufficient endogenous phytase activity to break down phytate into absorbable inorganic phosphorus.
It can form complexes with minerals such as Ca and Zn, reducing their availability and absorption, which can lead to mineral deficiencies and negatively affect the health and growth of pigs.
Therefore, pig diets are usually supplemented with phytases to improve the digestibility of P and other compounds bound to phytic acid phytates, such as proteins.
NON-PHYTIC PHOSPHORUS
Non-phytic phosphorus (NPP, Non-Phytic Phosphorus) is present in more readily bioavailable forms, such as inorganic phosphates and phosphoric esters.
They are more easily absorbed in the digestive tract of pigs without the need for specific enzymes for their release.
However, this does not mean that NPP is fully digestible in all raw materials.
This has led to confusion when establishing the P requirements of pigs in terms of available P ( Available P), assuming that all NPP was available.
Not all NPP is 100% available, so these concepts will be analyzed when discussing the digestion, absorption, and use of P in pigs and new ways to analyze and measure P digestibility.
The second part of this content will be published in the next edition of nutriNews International

A day in the life of phosphorus in pigs. Part I DOWNLOAD ON PDF
Gerardo Ordaz Ochoa, María Alejandra Pérez Alvarado, Luis Humberto López Hernández
National Center for Disciplinary Research in Animal Physiology and Improvement, INIFAP, Mexico
Adequate nutrition for both sows in the breeding herd and boars is essential to ensure health and reproductive performance in pig production. However, the increasing use of oxidized fats in the diet of breeding herds with the supposed aim of reduce feed costs raises uncertainty due to its impact on health and reproduction.


During feed processing and storage, especially of feeds rich in lipids, oxidation reactions can be induced in fats (factors that have already been addressed in previous editions of nutriNews International). Studies have shown that the consumption of oxidized fats can have side effects on the reproductive health of animals.
For example, lipid oxidation can cause oxidative stress in tissues, which is associated with cell damage and reproductive dysfunction (Yang et al., 2023).
Oxidative stress in the tissues of breeding sows, associated with the consumption of oxidized fats, is due to the excessive production of reactive oxygen species ( ROS) and the decrease in endogenous antioxidant levels (Figure 1; Su et al., 2017).
Oxidized lipids in the diet can increase lipid peroxidation levels in sow tissues, leading to the accumulation of oxidation products and damage to cell membranes (Luo et al., 2018), directly affecting:

1 2 3 4 Increase Abortion Incidence Reduce Conception Rate Reduce Oocyte Quality
Estrous Cycle Disorders

Figure 1. Levels of vitamins E and C, glutathione peroxidase (GPx), and total superoxide dismutase (SOD) in breeding sows according to oil type and antioxidant addition. Modified from Su et al., 2017.
In addition, oxidative stress can affect endocrine function of sows, altering the production and release of reproductive hormones.
Exposure to oxidized fats can alter gene expression related to hormone synthesis and metabolic function in sows, which may further compromise their reproductive health (Valle et al., 2009).
These findings highlight the importance of avoiding the use of oxidized fats in the diet of breeding sows to preserve their reproductive health.

Sows fed diets rich in oxidized fats have a significantly lower conception rate compared to those fed diets made with good quality (non-oxidized) fats.
Several mechanisms may explain how toxic compounds generated by fat oxidation affect sow fertility, including:
1
The oxidation of fats produces toxic compounds, such as aldehydes and peroxides, which can interfere with various physiological processes, including reproduction. In this case, there is an association between the consumption of oxidized fats and a decrease in the conception rate in sows (Zeng et al., 2023)
Negative impact on the animals' hormonal homeostasis , altering the production and release of key hormones involved in reproduction, such as estradiol and progesterone.
2
Reduction in feed intake during lactation, which in turn leads to poor body condition in females, resulting in low egg viability and, therefore, lower fertility in the next reproductive cycle (Figure 2).
3
Inflammatory responses in the body, which in turn can affect the health of the reproductive tract and the viability of eggs and sperm.
kg
in

Figure 2. Productive performance of sows and piglets during lactation and milk quality of sows according to the type of oil and addition of antioxidants. Modified from Su et al., 2017.

The quality of offspring is crucial for successful pig production, and maternal nutrition plays a key role in their development.
The consumption of oxidized fats by breeding sows has repercussions on the quality of offspring, both in terms of viability and productive performance.

It has been reported (Xu et al., 2021) that prenatal exposure to oxidized fats can affect fetal development and neonatal viability in pigs by:
An increase in the incidence of congenital malformations and decreased birth weight in litters of sows exposed to diets with oxidized fats (Gao et al., 2023).
Alteration of gene expression and metabolic function in offspring, which may have long-term effects on their health and productive performance (Zeng et al., 2023).
These effects on the quality of the offspring of sows that consumed diets rich in oxidized fats may be partly associated with:
The consumption of oxidized fats can have several adverse effects on the reproductive health of boars, affecting semen quality and testicular function (Zeng et al., 2023).

Toxic compounds that can have negative effects on fetal development, interfering with the formation of important organs and systems.
Increasing the susceptibility of piglets to diseases and metabolic disorders in the postnatal stage.
Reduction in sperm motility

Reduction in sperm concentration

Increased incidence of sperm abnormalities
The mechanisms behind the negative effect of oxidized fat consumption in boars are not yet fully understood, but its effects have been reported due to:
Oxidative stress in the body a ects cellular health and the function of reproductive organs.

Disruption of hormonal synthesis and testicular function, resulting in reduced semen production and quality.
Oxidative stress induced by the consumption of oxidized fats in the diet of breeding females and boars induces lower reproductive and productive efficiency for the pork industry.
Therefore, there is a need for greater attention to:
The quality of the fat used in diets.
Proper storage of raw materials.
Proper formulation of feed for breeding animals.
Fat oxidation can impair the synthesis of essential lipids required for maintaining cell membrane integrity, thereby a ecting sperm function.

It is crucial to implement antioxidant supplementation beyond reducing oxidation in feed, but also to reduce oxidative reactions in the animal caused by other stressors.
Therefore, more research is needed to increase understanding of the mechanisms behind the adverse effects of oxidized fats on reproductive indicators in sows and boars, as well as to develop effective strategies to mitigate these effects.
The use of oxidized fats in the feed of breeding sows and boars can have significant repercussions on health and reproductive behavior, as well as on the quality of offspring in pig production.
Adverse effects include decreased conception rates, increased incidence of abortions and reproductive disorders, as well as negative impacts on the viability and performance of offspring.


Therefore, it is crucial to adopt feeding practices that minimize the exposure of breeding animals to oxidized fats, thus ensuring their health and reproductive success.

The use of oxidized fats in pig feed: the breeding herd. Part II
DOWNLOAD ON PDF

Juan Gabriel Espino Independent nutritionist

The hoof health of pregnant sows has become a culling condition. This event can reach culling rates of between 5-10% of the breeding herd, which warrants analyzing its causes in order to take the appropriate measures.
In addition, the culling of pregnant sows due to hoof problems not only affects meat production but also increases operating costs due to the need to replace the culled animals.
It is therefore crucial to investigate and understand the underlying causes of these conditions. Among the potential solutions, adequate supplementation with specific minerals can play a key role in improving the hoof health of pregnant sows, reducing culling rates, and optimizing the overall production of the breeding herd.



The hind hooves are usually the most affected. There are several conditions that can affect the hoof health of sows:
We must understand that pregnancy causes weight gain in animals. This increase can be around 30 kg. The pressure of all this weight falls on the sow's hooves and/or phalanges.
It is well known that sows must mobilize their body reserves to support the fetuses in their wombs. Lipid and protein tissue are mobilized to provide the nutrients necessary for the growth and development of piglets. However, they also mobilize minerals to support the bone development of their offspring.
Hoof lesions in sows cause a decrease in feed intake, which can lead to nutrient deficiencies in the animal. If this situation is not corrected, subsequent farrowing performance may be affected.
A sow's hoof is mainly composed of keratin, a structural protein rich in cysteine, which forms disulfide bonds to provide strength.
If the animal remains in a gestation cage, its mobility is limited. In this situation, there is no natural wear and tear and the hooves begin to malform. Lack of exercise means that anatomical structures (muscles or cartilage) do not have the strength to promote efficient hoof health.
Collagen also plays an important role in the underlying dermis of the hoof, providing support and flexibility.
The collagen present in the hoof structure is classified into three types:

Type 1: predominant in the dermis of the hoof, providing resistance and structure.
Type 2: Found in smaller proportions, it contributes to tissue elasticity and regeneration.
Type 3: part of the basement membranes that support the epidermis of the hoof.
The following figures show the anatomical structure of pig hooves.

Figure 1. Rear view of the hoof. Image courtesy of Zinpro Corporation, Guide to lesion classification.
Deep digital exor tendon

Extensor tendon
Coronary band
Interphalangeal joint
Zinc is a trace mineral involved in more than 300 enzymatic reactions in a pig's body, many of which are related to growth, healing, and skin and hoof integrity. Some key functions of zinc in hoof quality:
Zinc is a cofactor of keratinase, an enzyme that regulates keratin formation in the hoof. Its deficiency causes cracks, flaking, and brittle hooves.
Keratin needs disulfide bonds for strength. Zinc participates in the activation of enzymes that stabilize these bonds.
Adequate zinc supply improves cell proliferation and collagen synthesis, accelerating damage repair. In sows with foot lesions, zinc helps reduce inflammation.

Figure 2. Longitudinal section of a hoof Image courtesy of Zinpro Corporation, Guide to lesion classification.
This figure shows the keratin coating around the phalanges. This structure is a thin covering that protects the ligaments and phalanges.
Symptoms of zinc deficiency in sows are:
Brittle and cracked hooves
Parakeratosis
Poor wound healing on hooves
Recurrent lameness
Copper is another mineral essential for hoof health, as it participates in collagen formation and disulfide synthesis in keratin
Copper activates lysyl oxidase, a key enzyme in the formation of type 1 collagen and elastin in the hoof dermis. Copper deficiency can weaken the hoof structure, making it more susceptible to injury.
Manganese is an essential mineral for the formation of connective tissue and cartilage, which directly influences hoof quality.
Some functions of manganese in the hoof:

2. Formation of disulfide bonds in keratin
Copper stabilizes keratin, improving hoof hardness and resistance. Its deficiency can cause soft hooves that are prone to fractures.
Antioxidant activity
Copper is part of superoxide dismutase (SOD), an antioxidant enzyme that protects the hoof from oxidative damage and mechanical stress.
1. Synthesis of glucosaminoglycans and proteoglycans
Manganese is essential for the production of chondroitin sulfate and glucosamine, which strengthen the hoof and prevent deformities.
2. Prevention of foot lesions
A diet with optimal levels of manganese reduces the incidence of cracks and deformities in the hoof.
Manganese activates the manganese-dependent enzyme superoxide dismutase, which protects the hoof from oxidative stress. This enzyme participates in bone formation, which helps structural stability.

Signs of copper deficiency in sows are described as:
Weak and brittle hooves
Decreased hoof elasticity
Increased incidence of lameness and hoof deformities
Symptoms of manganese deficiency:
Deformed hooves or hooves with longitudinal cracks
Increased risk of arthritis and joint problems
Difficulty healing hoof lesions

Hoof health does not depend solely on the minerals described above. It is also closely related to other nutrients:

These are essential for keratin synthesis. Deficiency can cause weakness in the hoof structure.
This nutrient improves keratin hardness and prevents hoof cracks. A daily intake of 10 mg of biotin is recommended to reduce hoof problems
They improve hoof elasticity and reduce inflammation in cases of foot injuries.
Promotes regeneration of the epithelial tissue of the hoof. Deficiency can cause defective keratinization.
These antioxidants reduce oxidative stress and improve connective tissue health.
1

2
DESCRIPTION OF THE LESION MILD MODERATE SEVERE
3
ACCESSORY TOES HEEL OVERGROWTH AND EROSION HOOVES

Slight growth and/or erosion of the soft tissue of the heel

Numerous fissures with obvious overgrowth and erosion

Large area of overgrowth and erosion with multiple cracks
Some nutrients included in the diet, such as minerals (zinc, copper, and manganese), are essential for hoof quality in sows, as they are involved in the synthesis of keratin, collagen, and connective tissue.
Insufficient intake of these minerals can cause brittle hooves, cracks, and lameness, affecting productive performance and animal welfare.

Small separation at the heel/ sole junction

Extensive separation of the heel/ sole junction

Extensive and deep separation of the heel/sole junction

Superficial and/or short separation along the white line

Long separation along the white line

Long and deep separation along the white line
Figure 3. this figure shows the different degrees of injury to a hoof. All degrees cause discomfort to the sow, affecting her performance. If the lesion is very severe, the sow should be culled at an early age. Images courtesy of Zinpro Corporation, Guide to Lameness Scoring.
Minerals and the health of the hoof of a pregnant sow DOWNLOAD ON PDF

Going one step beyond in animal nutrition means ceaseless research and development. Going one step beyond means anticipating developments in the livestock industry and offering the highest quality products and services. Going one step beyond means total commitment to overcoming all our customers’ challenges.

Gwendolyn Jones, PhD
Freelance Journalist

As the global egg industry faces mounting pressure from shifting climate conditions, economic uncertainties, and heightened sustainability demands, nutritionists and producers alike are turning to alternative feed ingredients that can help balance performance, cost, and environmental impact.
Among the promising options gaining renewed attention is hybrid rye—a modern cereal crop that offers advantages in yield stability, nutrient density, and adaptability to various growing conditions.
Once considered a niche ingredient, hybrid rye is now making its way into commercial layer diets thanks to advances in breeding and a growing body of nutritional research.

Its fiber profile, protein content, and digestibility have been reevaluated under contemporary production systems, offering new opportunities to formulate efficient, sustainable diets without compromising hen health or egg output.
Hybrid rye has the potential to help satisfy increasing demands on laying hen production resulting from greater climate variability, as well as challenging farm economics and requirements to reduce the environmental impact.
What matters is the right know-how to feed it. This article highlights some of the latest research.
From precision formulation strategies to insights on gut health and environmental performance, this article explores how hybrid rye can become a valuable component in the toolbox of modern egg production.



The need for more sustainable farming practices has led to exploring alternative feed ingredients that minimise the environmental impact while providing essential nutrients. Hybrid rye is an attractive crop, because it has greater yields than conventional varieties and other small grains.

It is less susceptible to fungal contamination, e.g. ergot and as a result, requires fewer and cheaper fungicides. Input costs are reduced further, due to lower requirements for nitrogen and pesticides.
Unlike open-pollinated conventional rye varieties, hybrid rye is the outcome of controlled crossbreeding between two distinct parent lines. This introduces genetic diversity and enhances desirable traits.
Poultry producers are reluctant to feed rye, due to adverse effects on poultry performance with conventional rye varieties in comparison to other grains seen in the past.


On top of that, hybrid rye is more drought tolerant and requires less water/ha, providing more consistent yields over time.
Due to its resilience, this winter crop outperforms spring cereals under challenging conditions, making it more adaptable to climate variability.
As hybrid rye requires less nitrogen fertilizer, it is a suitable candidate for efforts to reduce the carbon footprint of production. At the same time, it can lower the cost of feed.
The negative effects of rye were related to the levels of antinutritional factors, mainly the water-soluble fraction of non-starch polysaccharides (NSPs), but also ergot.
The bird’s digestive enzymes are not capable of degrading NSPs, especially arabinoxylans.
The high concentration of soluble NSPs in rye grain increases digesta viscosity, which reduces the digestion and absorption of nutrients, including minerals. The resulting impaired gut function can lead to depressed
One way to optimize the inclusion of rye in laying hen diets and overcome the antinutritional effects of NSP is the enzymes, such as xylanase (breaks down arabinoxylans), ß-glucanase (hydrolysing ß-glucans) supplemented to poultry diets as feed additives.
Scientific reviews report that most experiments with poultry confirmed that the addition of NSP degradative enzymes can reduce the viscosity of the intestinal content through the hydrolysis of plant soluble polysaccharides.
Although most trials showed that there was a greater negative response in broilers than laying hens. Furthermore, it has been shown to increase the incidence of wet litter, which can lead to footpad dermatitis.
However, new types of hybrid rye have been developed, which have shown to contain a reduced amount of antinutritive compounds.
This was irrespective of what kind of grain was used. However,





Emerging research with new hybrid rye varieties with lower NSP content is showing some promising results in laying hen experiments with inclusion rates of up to 25% in layer feeds.
A study using different levels of hybrid rye (0%, 10%, 15%, 20% or 25%) in laying hen diets showed that egg and eggshell quality indices were unaffected by dietary rye grain. However, rye inclusion significantly decreased yolk colour and increased the viscosity of digesta.
Research investigating the effects of hybrid grain on hen productivity and egg weight, showed no significant impact up to an inclusion level of 25% in the diet. However, some studies reported an increase in the viscosity of intestinal contents and a corresponding increase in the moisture of excreta.
Still, the supplementation of xylanase to the diet was able to reduce the viscosity of intestinal contents in response to diets with hybrid rye.


An increased rye level resulted in lighter yolks with a lowered share of redness and yellowness compared to those obtained from hens fed a control diet. Diet supplementation with xylanase had no significant effect on egg quality (except for yolk colour) but decreased the viscosity of intestinal content in laying hens.
Another study investigating the effect of a 25% inclusion of hybrid rye in laying hen diets for 25 weeks reported no adverse effects on egg shell quality at the end of the laying cycle. The addition of xylanase to the diet positively influenced eggshell thickness, in eggs from hens fed a rye–wheat–corn diet.
Also when whole hybrid rye grain was replacing ground wheat up to 20% in laying hen diets there were no negative effects on egg quality parameters.
An interesting finding from research carried out in Poland was that the inclusion of hybrid rye in laying hen diets reduced the amount of saturated fatty acids and increased unsaturated fatty acids in egg yolk. This could pose a beneficial nutritional effect for consumer health.
Mineral-metabolism-related disorders and bone weakness in laying hens, which affect both the effectiveness of the production cycle, and the overall welfare of the hens can be a serious problem.
There are several factors including genetic, environmental and endocrine factors that can affect the quality of bones in laying hens.

A more recent study evaluating the effect of the inclusion of hybrid rye in wheat-corn based mash diets on bone quality concluded that hybrid rye varieties can be introduced to this diet at 25% replacing corn without adverse effects on bone structure from the age of 26 to 50 weeks.
However, nutrition is acknowledged to be the most important factor, as it plays an important role in the regulation of bone homeostasis.
There are studies that have shown that the presence of NSP-rich grains in poultry diets affects bone quality parameters.

Current research data suggest that egg producers can be confident that feeding up to 25% of hybrid rye with decreased NSP content, in laying hen diets causes no adverse effects.
This has the potential to lower the cost of feed, as well as the carbon footprint of egg production.
It can help to make production systems more resilient to climate variability.
Layer feeds including 25% of hybrid rye can be further optimized with the inclusion of NSP enzymes, such as xylanase.
However, xylanase enzyme supplementation (200mg/kg of feed) is recommended, as it improved bone strength and quality. A possible explanation
Generally the risk of adverse







Edgar O. Oviedo Rondon
Prestage Department of Poultry
Science, North Carolina State University

Infertility is becoming a common problem in broiler breeder production. Data published in March 2025 in the Journal of Poultry Science by a research team led by Dr. Giridhar Athrey from Texas A&M University indicated that hathability of broiler breeders has been rapidly decreasing in the United States over the past decade.
This group used data from the USDA National Agricultural Statistics Service from 2013 to 2022, estimating that hatchability rates could decrease to approximately 60% by 2050 if no corrective actions are taken.

This alarming value underscores a crucial factor that can significantly impact the productivity of the broiler industry.
These authors concluded that infertility is the leading cause of reduced hatchability, but their data do not support this conclusion, as they did not include embryo diagnosis data.
Egg management, and other incubation factors, together with egg contamination, are also significant contributors to hatchery losses.
However, we can make a similar prediction about hatchability using data from AgriStats, which we published in AviNews International in March 2024 (Figure 1).
AgriStats is the largest benchmarking company in the United States and may have more updated and complete data. Presently, Agristats data does not include reports of fertility. However, multiple scattered reports from poultry veterinarians and broiler breeder managers indicate that infertility is also on the rise.

Fertility can be affected by both males and females; however, generally, each male is responsible for fertilizing around 1,000 to 1,800 eggs or more in commercial flocks. Stressors, mycotoxicosis, toxicosis, and aging can impair male reproductive capacity, including fertilizing ability.
Roosters aged over 40 to 45 weeks tend to exhibit:
Testicular regression
Sperm concentration
Viability
Forward mobility
Roosters over 40 weeks
Reductions in testosterone levels
Sexual behavior
Semen volume
Levels of polyunsaturated fatty acids, particularly omega-3, as well as type of proteins in the seminal fluid, antioxidant levels, and increase lipid peroxidation

Management practices like spiking and intra-spiking are generally effective strategies for maintaining fertility in aged broiler breeder flocks. However, spiking raises concerns about biosecurity and variation in progeny size when younger males are used.
The detrimental effects of aging in roosters can be mitigated by closely monitoring nutrient levels, feeding practices, and the use of feed additives.

The decision to establish specific diets for males, particularly during the egg production phase, is a topic of frequent debate in the rearing of broiler breeder males. This is because the amino acid and calcium requirements of roosters are lower than those of hens.
There are nutrient recommendations from genetic companies for male diets
Excessive calcium uptake by spermatozoa can lead to mitochondrial degeneration, a condition observed in roosters with low sperm motility.
Recent proteomic studies observed that some roosters express proteins in the seminal fluid that may regulate calcium uptake by spermatozoa, thereby minimizing this issue.

In many farms, insufficient control in feeding each diet separately can make it challenging to determine which option is better, as males also may consume some female feed.
In all breeder flocks, there is variability in the response of roosters to each diet type. For example, considering only the calcium level, it is known that in chickens, calcium plays a primary role in determining sperm motility.

A common agreement is that aging causes a reduction in the antioxidant capacity of the reproductive organs of roosters. The sperm plasma membrane of roosters has high concentrations of polyunsaturated fatty acids (PUFAs), especially docosatetraenoic acid (22:4n-6), which is highly susceptible to peroxidation.

The concentrations of this PUFA in sperm plasma membranes is four to five times higher in roosters than in sperm of mammalian males.

Consequently, increasing omega-3 PUFAs and antioxidant capacity with higher dietary intake of feed additives that have this property has been a strategy to maintain fertility in aging roosters.

have improved fertility in roosters of different genetic lines. These effects could be due to higher levels of eicosapentaenoic (EPA; C20:5 n3) and docosahexaenoic (DHA, C22:6 n-3), improved energy production by the activation of beta-oxidation in the spermatozoa that increases their forwardmotility, and enhanced testosterone synthesis by the testicular Leydig cells, semen volume, sperm viability, and total sperm count.
However, there are differences in the responses to the inclusion levels of these oils in rooster fertility because avian species and poultry genetic lines differ in their fatty acid desaturation and elongation processes, and consequently, in the generation of EPA and DHA.
The supplementation of omega-3 PUFAs with fish oils like:
4% salmon
3% tuna
2% menhaden,
2 to 6% linseed (flaxseed) oil
To improve broiler breeder male fertility, several antioxidants have been employed. Vitamin E deficiency has been shown to impact the fertility of avian males negatively.
However, various studies have yielded conflicting results regarding the additive effects of vitamin E and ascorbic acid on male fertility.

For example, dietary supplementation with low doses of vitamins C and E did not show any impact on spermatozoal quality; however, high amounts (300 mg/kg vitamin C and 150-200 mg/kg vitamin E) of these vitamins decreased the number of spermatozoa per milligram of epididymis. They increased the percentage of spermatozoa with misshapen heads.

Furthermore, Leydig cell formations appeared to be less developed in the basal-fed birds, which negatively affected testosterone production and secretion, as well as ejaculate volume and spermatozoal concentrations.
In contrast, positive results have been obtained by supplementing with another antioxidant, such as trimethylglycine, also known as betaine, at a dose of 1,000 mg/kg.
In older roosters, 300 mg CoQ10/kg of feed increased sperm production, motility, membrane integrity, and fertility percentage due to enhanced seminiferous tubule diameter, germinal cell layer thickness, and seminal antioxidant status.
In testes, from Selenium-deficient roosters and toms, fewer Sertoli cells and hierarchies of spermatogonia were committed to spermatid formation than those fed Selenium (0.3 mg of Se/kg).
The Selenium-methionine and other sources of selenium (sodium selenite Na2SeO3 or nanoSe) are beneficial in semen quality and testis development for older (>55 weeks old) roosters or under injection of dexamethasone, heat stress, and cadmium intoxication, but not always mitigates infertility and on occasions, high doses (>0.4 mg/kg) be detrimental in some experiments.
Related to other trace minerals, Zinc (Zn) supplementation has been one of the most investigated for male broiler breeders. Organic Zn supplementation (100-110 mg Zn/kg diet) increased gonadal maturation, enhanced IGF and testosterone, testicular histology, improved semen quality, morphology, and motility, and consequently fertility


Research studies have demonstrated the positive antioxidant effects of several phytochemicals in improving semen traits, testosterone, and fertility in roosters, toms, and quails. The supplements evaluated with positive results include:
Curcumin from turmeric (Curcuma longa) at 0.8 mg/kg diet or 30 mg curcumin/rooster/d
Gingerol and gingerdione from ginger (Zingiber officinale) at 15 g of ginger root powder/kg diet or 100 μL of ginger essential oil/kg BW
Lycopene from tomatoes and fruits at 5 g/L or 0.05 mg/mL of drinking water
6 mg of canthaxanthin/kg diet
100 mg/kg of astaxanthin
50 mg of chrysin (5,7-dihydroxyflavone a flavonoid and polyphenol) per day
5 mg of soybean isoflavones per kg of diet
Rosemary leaves at 5 g/kg diet
0.25 mg of cinnamon bark oil/kg diet,
20% inclusion of dried apple pomace
120 mg/bird of alpha-lipoic acid
Rooibos (Aspalathus linearis) at 3%
Black seed (Nigella sativa) or black cumin at 1.0%


The supplementation of L-arginine, endogenous amino acids, or metabolites such as D-aspartic acid, L-carnitine, and guanidinoacetic acid (GAA) has been demonstrated to improve the fertility of aged roosters over 55 weeks old.
L-arginine has been supplemented at 0.14% of the diet, D-aspartic acid at 200 mg/kg body weight, L-carnitine at 150 mg/kg diet, and GAA at 1,200 mg/ kg feed with positive effects on libido, testicular development, and semen quality. Mechanisms include enhanced testosterone plasma levels, development of the testes, and the formation of Sertoli, Leydig, and spermatogonia cells, as well as semen quality characteristics such as sperm concentration, membrane integrity, forward motility, and sperm penetration.

L-arginine produces nitric oxide and GAA, which are involved in fatty acid oxidation. GAA is required to make creatine, and in its phosphorylated form, phosphocreatine generates energy for the spermatozoid.
Several mycotoxins can negatively impact the reproductive organs of roosters, leading to reduced weights and potentially affecting semen quality. Specifically, diacetoxyscirpenol (DAS), a type of trichothecene, has been shown to induce degenerative processes in the testes, resulting in reduced size and impaired testicular function.
Other mycotoxins, such as aflatoxins, fumonisins, zearalenone, ochratoxins, and trichothecenes (including deoxynivalenol and T-2 toxins), are also associated with reproductive issues in poultry.
Then, mycotoxin binders and plans to minimize mycotoxin contamination and impact are essential.
D-aspartic acid and L-carnitine are involved in mechanisms to suppress lipid peroxidation. L-carnitine also participates in lipid metabolism by transporting long-chain fatty acids into the mitochondria to initiate fatty acid ß-oxidation.


Currently, herbicide-tolerant corn and soy varieties comprise 90 and 94%, respectively, of the acres of these crops planted in the United States, and glyphosate-tolerant varieties account for roughly 50% of corn and soy grown in the United States.
These glyphosate-tolerant cultivars are typically exposed to glyphosate-based herbicides (GBHs) throughout their production period, and due to their tolerance to glyphosate, crop production is unaffected.
Exposure to GBH ingredients through animal feeds, at even legal levels, can significantly influence the reproductive health of broiler breeder roosters. Both the gross histopathology of the rooster testis and sperm mobility, the most critical component of rooster sperm quality, are seriously impacted by exposure to GBH ingredients.
Research conducted by Zachery Jarrell at the University of Georgia demonstrated that the addition of humic acids reduces the effect of GBH.
In conclusion, infertility is a crucial issue to address in broiler breeder production, as it can contribute to reduced hatchability.
Male fertility has a significant impact that can be modulated with nutrition. Specific male diets tailored to their nutritional needs can help breeder managers better control rooster body weight and body composition.
Increasing antioxidant capacity through proper vitamin and mineral levels, supplementation with phytochemicals, and functional amino acids can be beneficial, especially for aging males.

Finally, avoiding mycotoxins and addressing their potential contamination with these toxins and others like glyphosate-based herbicides can help to minimize the infertility issues observed.
Nutritional Interventions to Improve Fertility in Male Broiler Breeders DOWNLOAD ON PDF

M. Naeem
Postdoctoral Fellow, Department of Poultry Science, Auburn University, USA
Introduction
The poultry industry is one of the most dynamic and rapidly growing sectors in global agriculture. With the increasing demand for chicken meat and eggs, poultry producers face the dual challenge of maximizing productivity while ensuring food safety and animal welfare.

In this context, organic acids have emerged as promising alternatives to antibiotic growth promoters (AGPs), offering a natural, safe, and effective way to enhance poultry health, performance, and sustainability.
Organic acids, also known as carboxylic acids, are widely used as feed additives in poultry diets due to their antimicrobial, growth-promoting, and gut health-enhancing properties.
Their usage has gained momentum globally, especially in the wake of rising concerns over antibiotic resistance and regulatory restrictions on AGPs.
This article explores the science, benefits, applications, and future potential of organic acids in poultry production.

Organic acids are weak acids containing one or more carboxylic acid groups (-COOH). They occur naturally in plants, animals, and microbial fermentation products.
In poultry nutrition, commonly used organic acids include Formic acid, Acetic acid, Propionic acid, Lactic acid, Citric acid, Butyric acid, Fumaric acid, Sorbic acid, Malic acid and Benzoic acid.
These acids can be used individually or in blends, often combined with their salts (e.g., calcium propionate, sodium formate) to improve stability, palatability, and targeted delivery in the gastrointestinal tract.
One of the key reasons for using organic acids in poultry is their potent antimicrobial activity. They inhibit the growth of pathogenic bacteria such as Salmonella spp., Escherichia Coli, and Clostridium Perfringens, which are common culprits behind foodborne illnesses and poultry diseases.


The mechanism by which organic acids exert their antimicrobial effect involves penetrating microbial cell membranes in their undissociated form. Once inside the cell, they dissociate into ions, leading to a reduction in intracellular pH and disruption of vital metabolic functions.
This disruption impairs DNA replication and enzyme activity, ultimately resulting in cell death. Notably, unlike antibiotics, organic acids do not contribute to the development of antimicrobial resistance, making them a safe and sustainable longterm strategy in poultry production.
Gut health is central to nutrient absorption, immunity, and overall bird performance. Organic acids support gastrointestinal integrity through several mechanisms.
They reduce gut pH, creating an unfavourable environment for pathogenic bacteria while promoting the growth of beneficial microflora such as Lactobacillus and Bifidobacterium.
Additionally, organic acids enhance the structure of the intestinal lining by increasing villus height and crypt depth, which leads to improved nutrient uptake. They also stimulate the activity of digestive enzymes like pepsin and protease, thereby enhancing protein digestion and overall feed efficiency.


Multiple studies have shown that supplementation with organic acids leads to significant improvements in poultry performance.
These benefits include enhanced body weight gain, better feed conversion ratio (FCR), improved egg production and quality, and greater survivability under stress conditions.
Organic acids, particularly citric and fumaric acids, also function as metabolic intermediates in energy production and nutrient metabolism.
Their role in these physiological processes contributes to more efficient growth and overall better performance in poultry production systems.

Organic acids are also used for preserving feed and sanitizing water. They inhibit mold growth, yeast fermentation, and bacterial contamination, thus reducing the risk of mycotoxins and spoilage.
Common uses include:
Microencapsulated Organic Acids
Encapsulation allows acids to bypass the stomach (proventriculus and gizzard) and release in the intestine, where they can act against pathogens more effectively.




In broiler production, organic acids are extensively used to enhance growth performance, improve feed efficiency, and resistance to enteric diseases.
Commonly incorporated acids such as formic, propionic, and citric acid are starter and grower to support early development.
Among these, butyric acid—especially in its encapsulated form—is gaining prominence due to its targeted action in the lower gastrointestinal tract,


For laying hens, organic acids contribute to:
Improved calcium absorption and eggshell quality.
Better egg production rates.
Reduced incidence of enteritis and drop in egg quality during stress periods.

Acidifying drinking water with organic acids is a practical strategy to improve poultry health and performance. This approach helps reduce microbial load in water lines, ensuring cleaner water for the birds.
Additionally, during periods of heat stress, acidified water encourages greater water intake, which is critical for maintaining hydration and performance. When feed intake drops, organic acids in the water can continue to support gut health.

Organic acids are often used in synergy with other natural feed additives for enhanced results:
Probiotics and prebiotics: Promote beneficial gut flora alongside pathogen control.
Essential oils: Enhance antimicrobial spectrum and palatability.
Enzymes: Improve nutrient digestion and reduce feed cost.
Phytogenics: Offer antioxidant and immunomodulatory effects.
Such combinations can act as holistic replacements for AGPs in antibiotic-free poultry production systems.
Commonly used acids for this purpose include formic, acetic, and lactic acids, all of which contribute to maintaining optimal gastrointestinal conditions.


Despite the many benefits, several factors influence the success of organic acid supplementation:
The effectiveness of organic acids depends on proper selection, inclusion levels, and whether they are used singly or in blends.

5. Cost-Effectiveness
While generally cost-effective, some encapsulated or proprietary blends can be expensive. Economic feasibility must be weighed against performance gains.


Young chicks or immunocompromised birds may respond differently to acid supplementation. Tailored programs may be necessary.
High buffering capacity of certain feeds (e.g., high protein or mineral levels) may neutralize acid effects, requiring dose adjustments.
4. Environmental Conditions
Acid stability and efficacy can vary with temperature, humidity, and water quality.

With the global shift toward antibioticfree and organic poultry production, organic acids align well with consumer and regulatory expectations.
In the European Union, the use of many organic acids is approved as zootechnical additives under Regulation (EC) No. 1831/2003.
Because organic acids are naturally derived and residue-free, they are wellreceived by consumers seeking clean-label and sustainable poultry products.

In the United States and other regions, they are generally recognized as safe (GRAS) and widely accepted as feed preservatives and acidifiers.
As research and technology advance, the use of organic acids in poultry continues to evolve:
Next-generation encapsulation: New delivery technologies aim to increase targeted release in the gut.
Precision feeding: Integrating organic acids with data-driven nutrition strategies for optimal results.
Synergistic matrices: Custom blends of acids with enzymes, herbs, or peptides for multifactorial benefits.
Genetic insights: Understanding bird genotypes that respond better to acid supplementation.
Sustainability assessments: Life cycle analysis to quantify the environmental benefits of using natural additives.

The use of organic acids in poultry production represents a paradigm shift toward more sustainable, safe, and efficient farming practices.
As natural antimicrobials, gut health promoters, and performance enhancers, they offer a viable alternative to antibiotics, meeting the demands of modern poultry production without compromising animal welfare or food safety.
While challenges remain in optimizing their use, the scientific and practical evidence overwhelmingly supports their role in poultry diets.
With continued research, innovation, and integration into holistic nutritional strategies, organic acids are poised to become foundational pillars of a healthier and more sustainable poultry industry.
Braulio de la Calle Campos
TD Ruminants Coren Agroindustrial SAU and Head of the Beef Cattle Department at Coren Cooperative Society

The inclusion of enzymes in ruminant diets is a key tool for optimizing their utilization, improving both efficiency and effectiveness. In addition, it helps to prevent metabolic diseases, which not only benefits the profitability of the farms, but also positions itself as a fundamental pillar for its sustainability.
Enzymes are proteins produced by cells to catalyze specific chemical reactions.
In the field of feed and feed processing, most of the enzymes used are of microbial origin, obtained mainly from:
Bacteria such as Bacillus subtilis, Bacillus lentus, Bacillus amyloliquefaciens, and Bacillus stearothermophilus.

Fungi such as Trichoderma longibrachiatum, Aspergillus oryzae, and Aspergillus niger.
Yeasts such as Saccharomyces cerevisiae.
The exogenous enzymes, which do not belong to the digestive system of animals, are incorporated into diets with the aim of increasing nutrient use efficiency and eliminate antinutritional factors.
In monogastric nutrition, their use is widely spread, especially with phytases and amylases, which are found virtually in all feeds for intensive systems. This is due to the inability of monogastric animals to produce certain enzymes necessary to digest some components of their feed, making exogenous enzymes indispensable for maximizing digestibility.


ruminants, the context is more complex due to the presence of the rumen, a unique ecosystem with a microbial population that plays a crucial role in the initial digestion
The enzymes produced by the ruminal microbiota are responsible for fermentation, helping in the digestion of starch and fiber. However, studies have shown that this process is not always efficient, especially when feeding slow-digesting grains. This incomplete utilization is due to factors such as:
The characteristics of the starch.
The physicochemical and biological conditions of the rumen.
The limited action of endogenous enzymes.
In ruminants, enzymes can:
AAct directly on feed in the rumen, promoting its digestion.

To improve fiber and starch degradation, the inclusion of exogenous enzymes in the diets of dairy and beef cattle is key.
These enzymes increase the extraction and absorption of nutrients, improving their availability and contributing to greater efficiency in animal production.
These enzymes catalyze degradative processes, transforming substrates into chemical compounds that are utilized by both ruminal microorganisms and the animal.
In this way, the complete digestion of complex structures, such as the cell wall of forage or cereal grains, involves a large number of enzymes.
BHave post-ruminal effects that enhance fiber degradation during intestinal digestion.

Types of enzymes according to their action in ruminants:
Fibrolytic: act on fibers.
Phytases: act on phosphorus. Amylolytic: act on starches.
Improve the digestibility of cell walls and starch.

Objectives of enzyme use in ruminants
Increase the efficiency of diets.
Optimize the use of low digestibility byproducts.

To maximize the energy potential of forage and achieve maximum productive performance, it is essential to understand what fiber is and how its chemical composition influences its digestibility and utilization by the ruminal microbiome.
The fiber, which constitutes a significant proportion of the cell wall of plants, is mainly composed of structural carbohydrates that are divided into fractions such as cellulose, hemicellulose, and lignin.
However, less than 50% of these components are easily digested, which limits their efficient use.
Complement the production of endogenous enzymes.
Increase the availability of carbohydrates.
Increasing the digestion of these cell walls by just 10% can make a noticeable difference, significantly reducing the solids present in manure.



To improve this process, the addition of fibrolytic enzymes to the diet is key, as they:
They stimulate fiber digestion.
They promote dry matter (DM) intake.
In this regard, a meta-analysis of 10 studies highlighted that the use of fibrolytic enzymes not only increases DM intake, but also increases milk production by an average of 2.3 kg/day, which translates into a 4.6% increase in feed efficiency.
Although ruminants, compared to monogastric animals, have a natural advantage in fiber fermentation thanks to the diversity of their ruminal microbiome, the digestion process is complex and occurs sequentially.
Anaerobic fungi play a crucial initial role, releasing enzymes such as xylanases and cellulases that weaken the cell wall of plants, thus facilitating the action of cellulolytic and hemicellulolytic bacteria specialized in the decomposition of cellulose and hemicellulose.

Fibrolytic enzymes act:
Enhancing the digestibility of dry matter and neutral detergent fiber (NDF).
Increasing the production of volatile fatty acids.
Increasing ruminal activity.
Despite these natural mechanisms, fiber digestion can be affected by external factors, with microorganisms being particularly sensitive to oxygen levels and variations in ruminal pH.
When the pH falls below 5.6 for prolonged periods, the population and activity of these microorganisms decrease, which reduces digestion efficiency and increases the risk of subacute ruminal acidosis (SARA).
This imbalance can negatively impact milk production, affecting nutritional parameters such as fat content, and cause fertility and locomotor problems, as well as compromising methane production.
Table 1. Effect of exogenous fibrolitic enzymes (EFEs) on the in vitro digestibility of dry matter (DM) in various agro-industrial by-products. The values correspond to the average obtained under control conditions and with the addition of EFEs, indicating the percentage improvement in digestibility for each by-product.


Amylolytic digestive enzymes play a key role in metabolic reactions related to the the conversion of complex starch molecules, such as amylose and amylopectin, into simpler components such as glucose, maltose, and isomaltose.
This activity, which is essential for the energy utilization of starch, is mainly carried out by extracellular enzymes produced by ruminal microorganisms such as Streptococcus bovis, Butyrivibrio fibrisolvens, Ruminobacter amylophilus, Prevotella ruminicola and Selenomonas ruminantium.
The effectiveness of these enzymes in the rumen depends on factors such as temperature, pH, and the quality of the diet mixture in the ruminal fluid.
However, these conditions are not always optimal, which opens up the possibility of incorporating exogenous amylolytic enzymes that act synergistically to improve starch digestion.
The mode of action of amylolytic enzymes includes the catalysis of starch hydrolysis into oligosaccharides in the rumen, optimizing digestion and promoting microbial activity.
This action is particularly beneficial to fibrolytic bacteria, which take advantage of the breakdown of starch to increase fiber degradation and protein production.
As a result, more energy is released in the form of glucose and acetate, which contributes to increased milk and fat production.
In cereal-based diets such as corn, where starch is the main source of energy, this improvement in ruminal digestion is particularly significant.
Amylases not only catalyze starch hydrolysis in the rumen, but also have general effects on improving digestive processes:
Increasing the rate of fiber and cell wall degradation.
Optimizing the synchronization between ruminal protein production and energy metabolism.
Stimulating microbial protein production.
There are complex interactions between the amount of fermentable starch and the digestibility of fiber in the diet.
For example, an improvement in the digestibility of fiber in one unit can translate into an increase of more than 0.15 kg in intake and 0.2 kg more milk corrected for 4% fat.

All of this translates into greater nutrient digestibility with a significant improvement in feed efficiency.
This is due to greater fiber digestibility increases dry matter intake, improves the energy density of the diet and, consequently, promote microbial protein production.
In lactating cows, low starch digestibility can be due to several factors, such as:
Particle size.
The physical properties of the grain.
Pancreatic amylase deficiency.
<4.5
When starch digestion is compromised, it is usually reflected in the feces.

A fecal starch content of less than 4.5% indicates total digestibility close to 90%, while a 1% variation in digestibility is equivalent to the energy needed to produce 0.33 kg of milk, provided that dry matter intake remains constant.
Starch digestibility (%) = x 100
Starch ingested


Although fecal starch digestibility generally ranges from 87% to 99%, it has been observed that a postruminal infusion of corn starch can have a digestibility of 5% to 20%.
This suggests a limited capacity of the ruminant small intestine to digest high levels of starch due to low pancreatic amylase secretion.
Therefore, improving starch digestion in the rumen allows more energy to be released for the ruminal fibrolytic flora, increasing its ability to digest forage and, consequently, reducing feed costs.
Trials conducted at world-renowned universities have confirmed the positive impact of using amylases in improving feed digestibility and milk production efficiency.
These enzymes not only optimize starch digestion, but also the digestion of fiber present in the feed, which increases the energy available to the cow and contributes to higher production performance.

The mechanisms of cross-feeding are an essential feature of the ruminal microbial ecosystem, as in this process microorganisms take advantage of the hydrolysis products generated by other species, resulting in more efficient and synergistic fermentation within the rumen.

The use of exogenous enzymes in animal nutrition is positioned as a sustainable alternative to maximize nutrient utilization, improve production indicators during the different stages of rearing, and facilitate the incorporation of new alternative sources into animal feeds.
In addition, these tools are essential for advancing the concept of precision nutrition, especially in ruminants.
The incorporation of exogenous amylases has proven effective in increasing ruminal degradability and improving fecal digestibility of starch in most cases.
Its use is particularly valuable in dairy cows during peak lactation, as it optimizes the utilization of starch-rich rations, maximizing productive potential.
On the other hand, the use of exogenous fibrolytic enzymes requires a detailed assessment of its impact, such as the possible increase in methane production, as well as their effectiveness in diets with different percentages of forage.
It is essential to adapt their use according to the characteristics of the diet and the production phase of the animals.
Finally, it is essential to ensure a positive return on investment (ROI) when implementing these strategies, which underscores the need for precise planning and a technical approach that ensures economic sustainability and production efficiency.

Use of enzymes in diets for ruminants: catalyzing efficiency and sustainability in livestock production DOWNLOAD ON PDF Similarly, these enzymes are useful in the final stage of fattening, contributing to performance during this critical phase.


